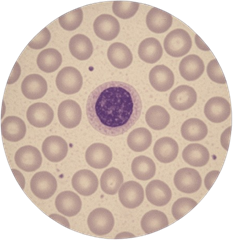

Microscope Applications
frequently asked questions
What types of microscopes are best for different applications?
Microscope International offers microscopes for over 25 application areas, including medical diagnostics, industrial inspection, environmental analysis, and research. Each category—such as pathology, metallurgy, or forensic science—features models engineered for its unique optical and workflow requirements.
Can one microscope be used for multiple applications?
While some microscopes are versatile, performance is best when matched to your specific use. For instance, a biological microscope optimized for tissue samples may not deliver the same results for material surface inspection. Choosing an application-specific microscope ensures accuracy, clarity, and durability.
Do you provide microscopes for industrial and materials science applications?
Yes. Microscope International carries advanced metallurgical, soldering, and measurement microscopes for industrial, manufacturing, and materials science use. These systems are designed for high precision, repeatable measurements, and detailed visual analysis.
How can I find the right microscope for my work?
You can browse microscopes by application on our site or contact our specialists for personalized recommendations. Our team will help you match optical performance, magnification range, and illumination type to your workflow and research goals.
What if my application isn’t listed on your site?
If you don’t see your specific field or project type, our experts can suggest alternative models or customized microscope setups that fit your requirements. We specialize in finding tailored solutions for unique or emerging use cases.
Not sure which piece of equipment you need, but know how you'll be using it? Check out our advanced and affordable products, organized by microscope applications.